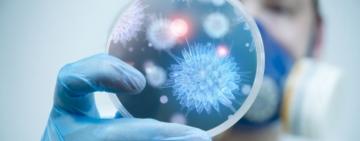
Одещина знову лідирує за кількістю хворих на COVID-19

Одещина знову лідирує за кількістю хворих на COVID-19
На Одещині за минулу добу зафіксували 1 232 нових випадків COVID-19 (232 962 з початку пандемії), — повідомляє МОЗ.<...

В Одесі побудують крематорий для тварин
В Одесі у районі 6-го кілометра Овідіопольської дороги виділили земельну ділянку для будівництва крематорію для тварин. Піч вже закуп...

Спеціалісти соціальної служби Теплицької громади стали учасниками обговорення гендерної рівності та запобігання насильству з експертками ГР «Віра, Надія, Любов»
2 грудня 2021 року у центральній бібліотеці м. Арциз відбулась зустріч експерток громадського руху “Віра, Надія, Любов” Костюк Ольги, Л�...

У Сараті вітали військовослужбовців з 30-ю річницею Збройних Сил України
6 грудня керівники громади відвідали військову частину, розташовану в селищі Сарата, привітали військовослужбовців з 30-ю річницею Зб�...

У Павлівській громаді діти з особливими потребами отримали допомогу до Міжнародного дня людей з інвалідністю
"3 грудня – особлива дата для людей з особливими потребами, яка нагадує нашому суспільству про проблеми дорослих та дітей з особливим�...

За прогнозами британських вчених COVID-пандемія закінчиться не раніше 2026 року
Вчені Науково-консультативної групи з надзвичайних ситуацій Великої Британії дійшли висновку, що коронавірус становитиме небезпеку...

Сьогодні в Ізмаїлі можна безкоштовно пройти тест на ВІЛ
Сьогодні, 5 грудня в Ізмаїлі можна безкоштовно пройти тест на ВІЛ.
До 15:00 години триватиме акція швидкого тестування на ВІЛ. Про це ...

Компанія Цукерберга просить користувачів надсилати їхні інтимні фото
Meta запустила захист від "порнозливів", для якого потрібно частково завантажити свої знімки в мережу наперед - на спеціальну платформу....

Байден анонсував "довгу розмову" з Путіним про Україну: що скаже президент США
Лідер Сполучених Штатів Джо Байден заявив, що зустріч із російським президентом Володимиром Путіним, запланована на найближчий тижд�...






